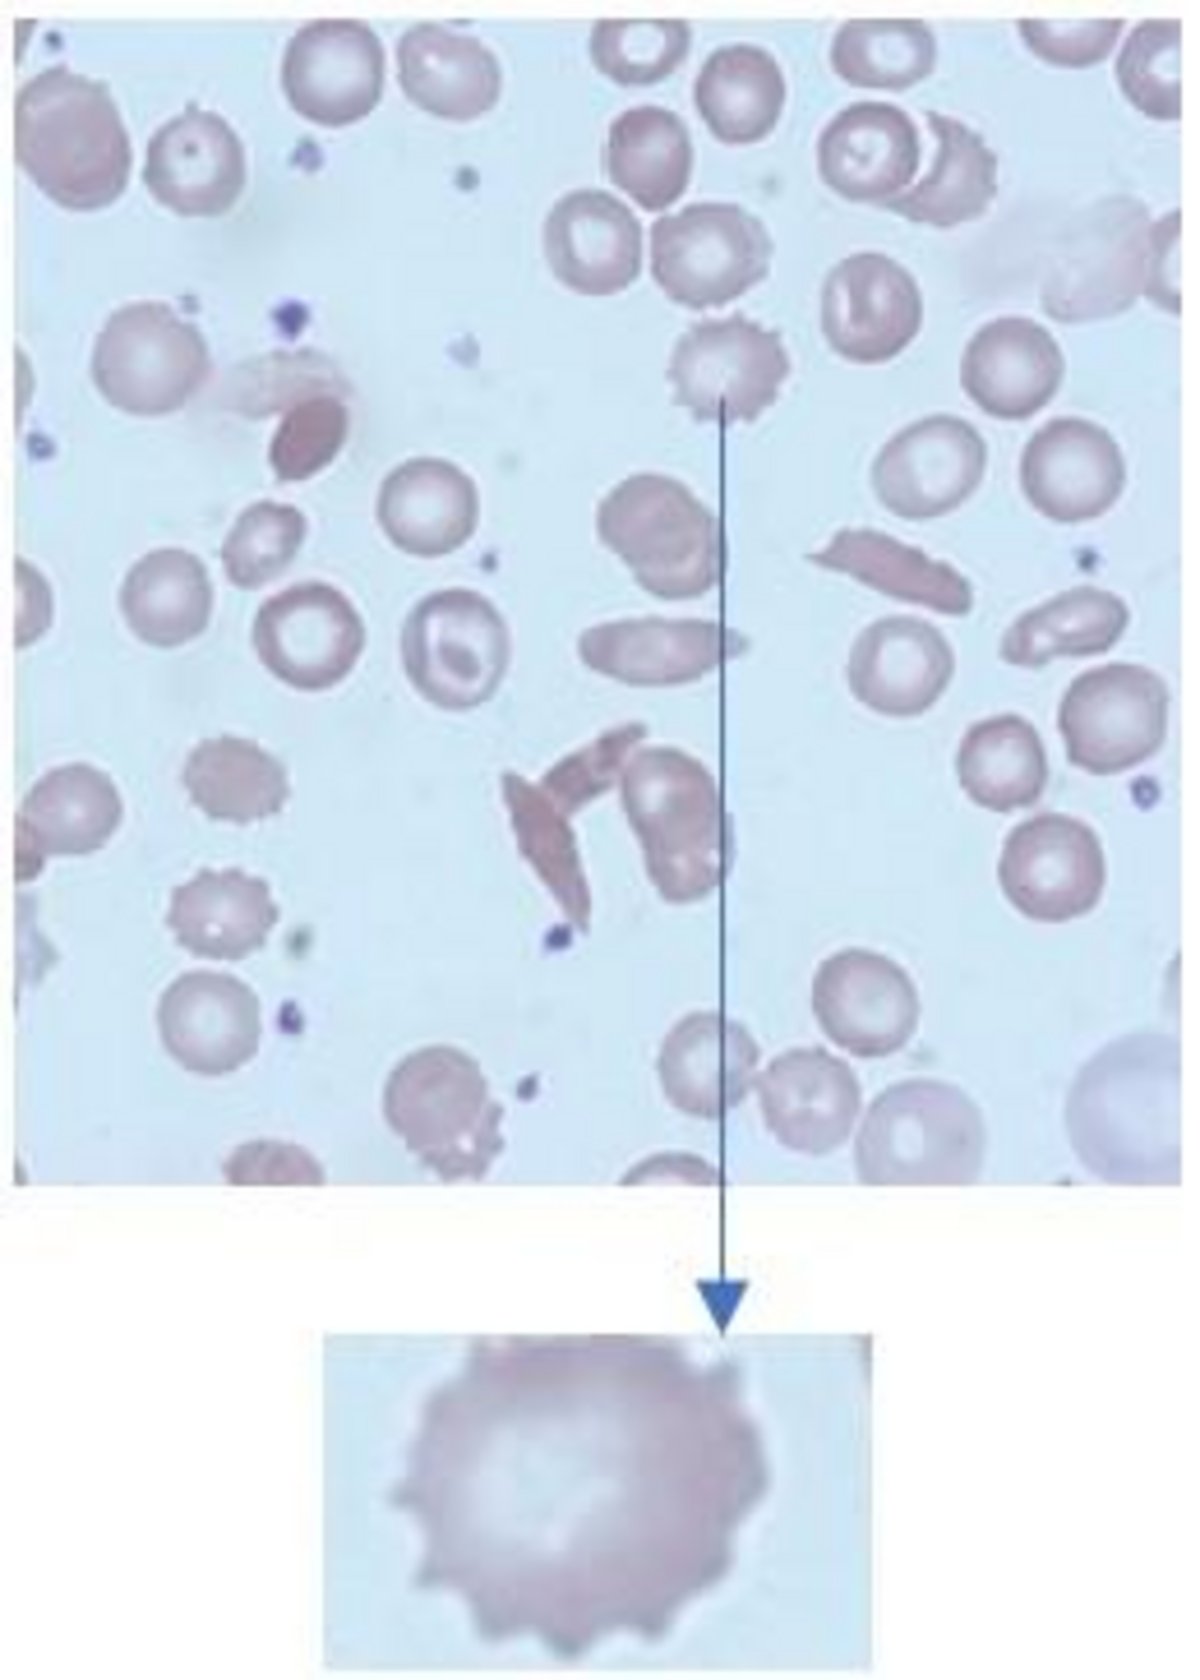
Case_study_cell_1 Case_study_cell_1
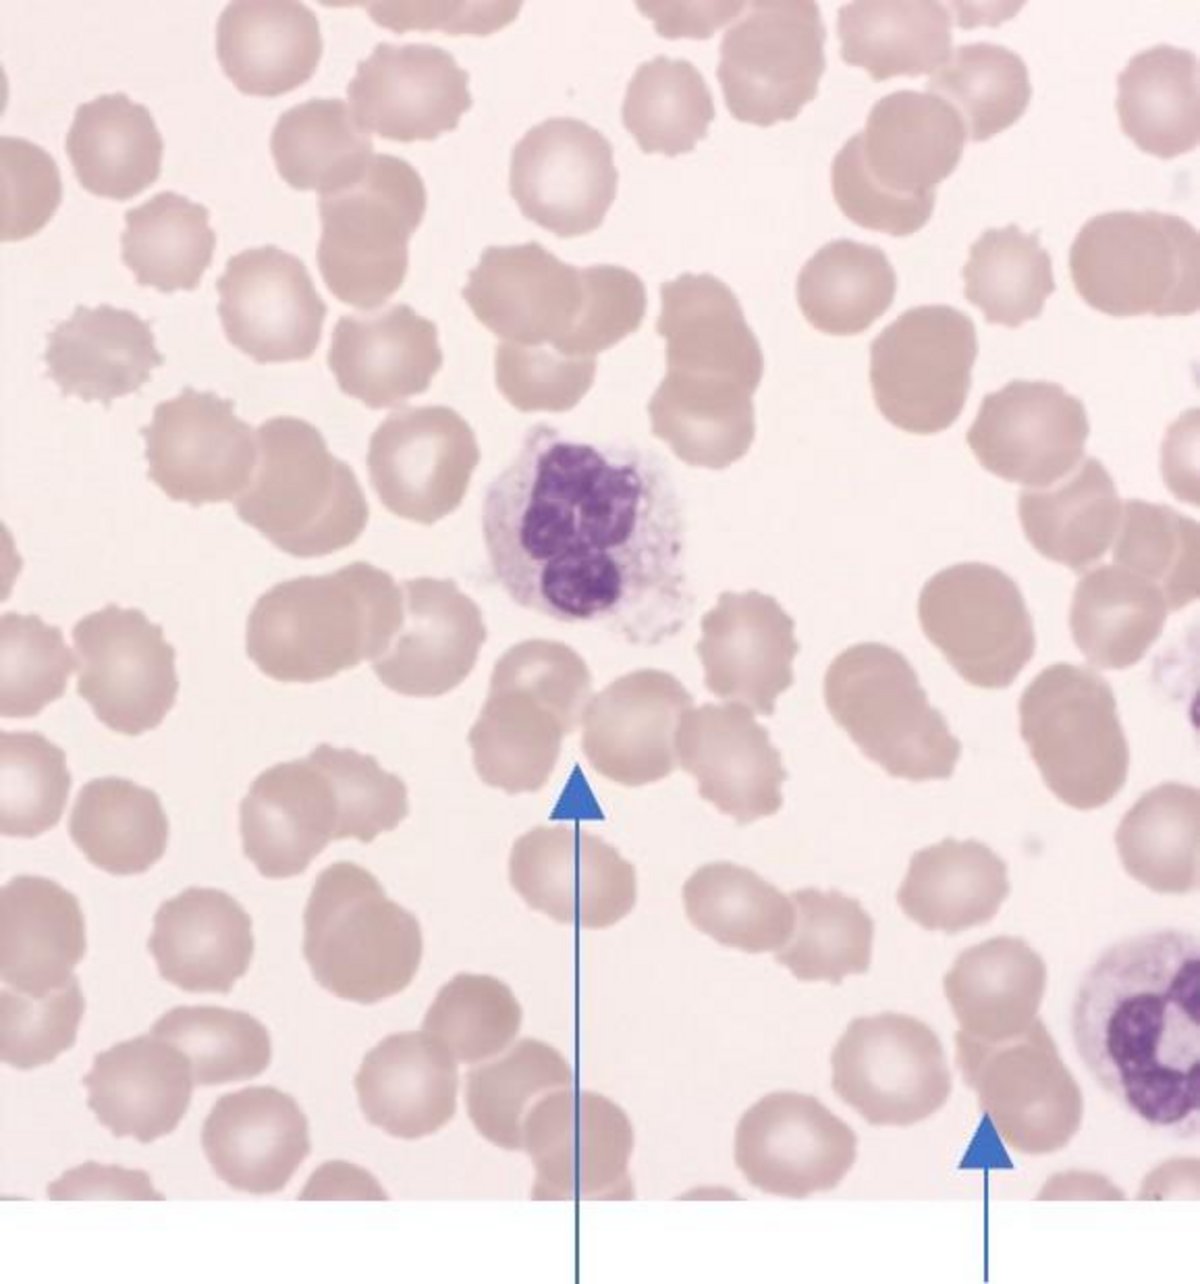
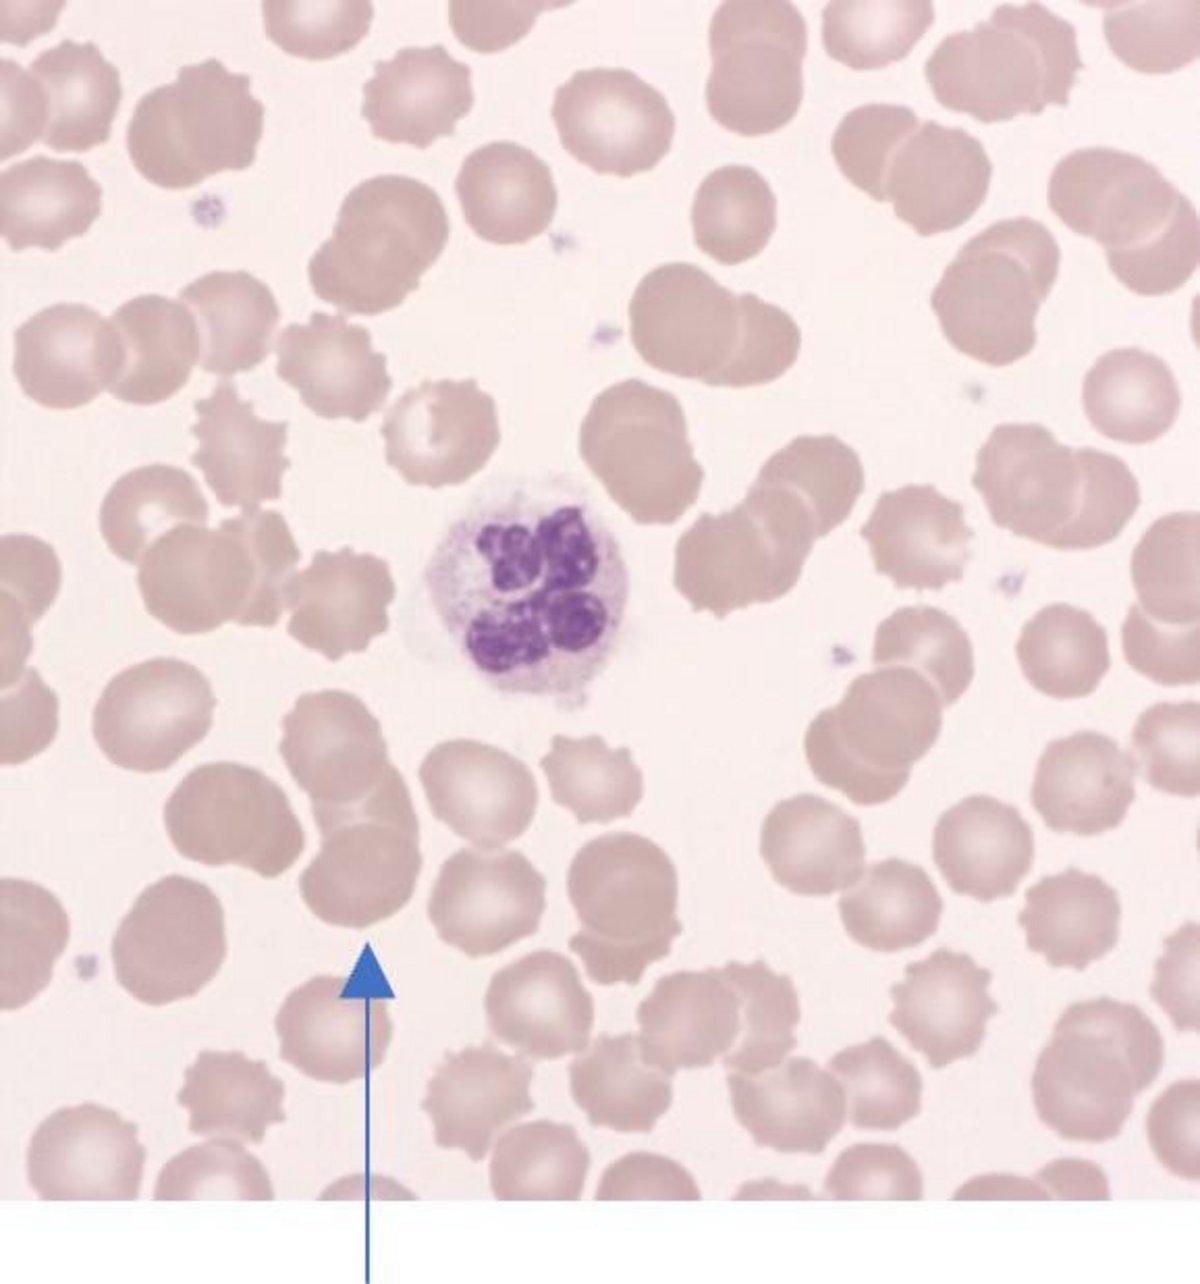
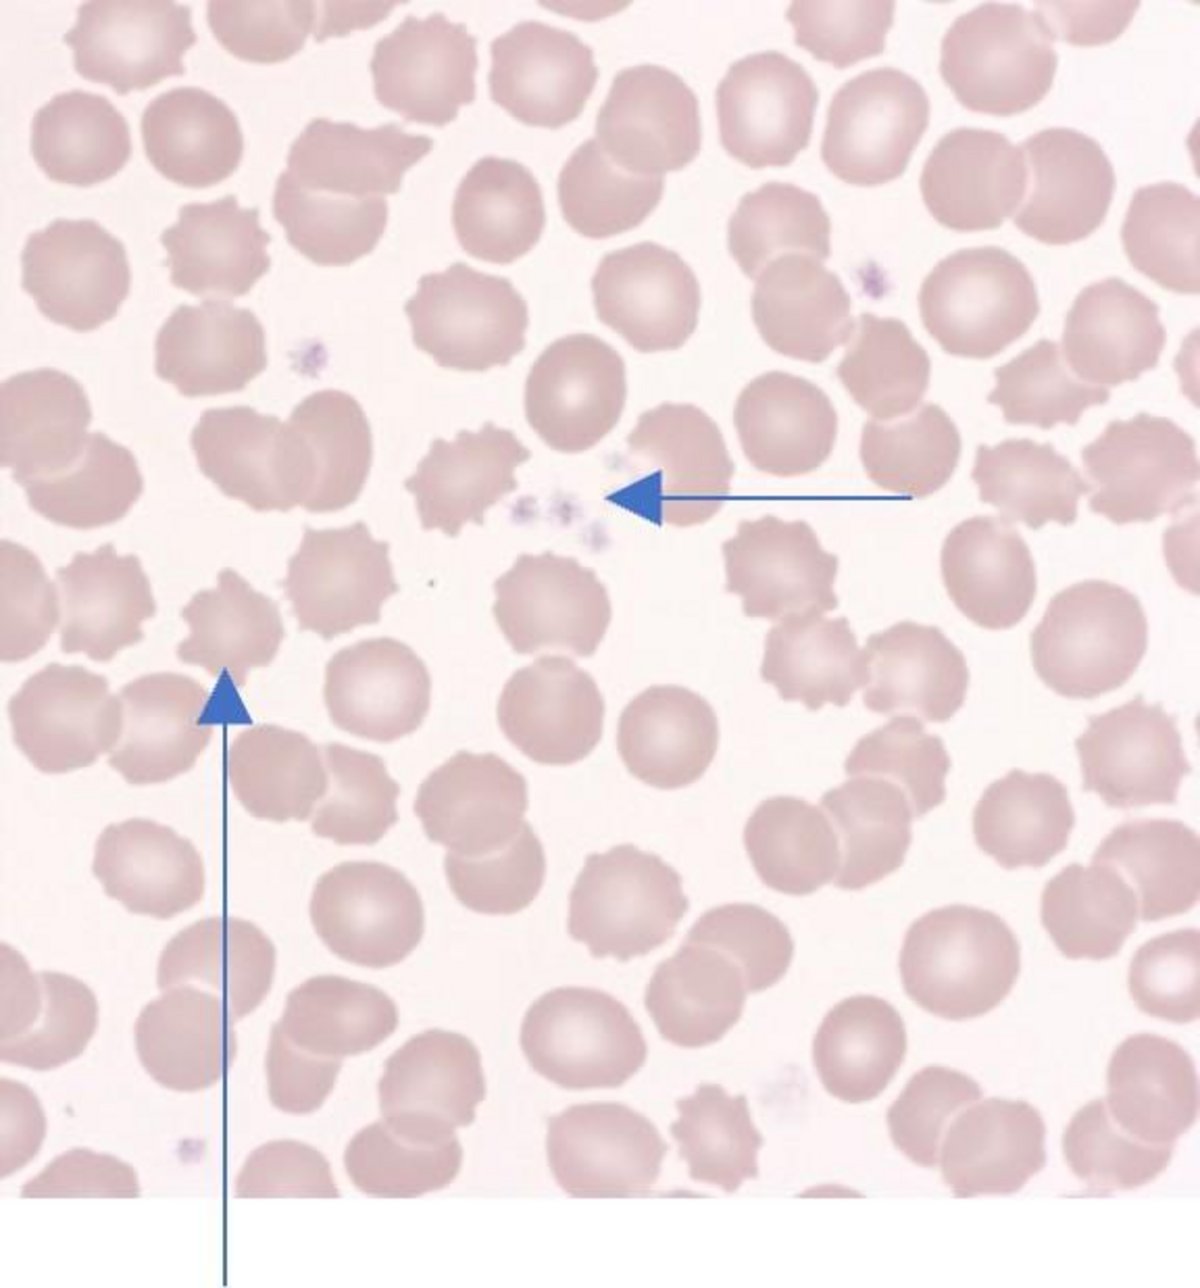

Subscribe now!

Subscribe and receive Heme Insights from the next issue.
► Morphology Case Study
► Aged Sample Effects on a Blood Smear
► Quiz
► PDF
Female (age not given)
| FBC | |
|---|---|
| WBC 11.20 (10^3/mm3) | MCH 29.8 (pg) |
| RBC 2.72* (10^6/mm3) | MCHC 34.9 (g/dL) |
| HGB 8.1* (g/dL) | PLT 519* (10^3/mm3) |
| HCT 23.2* (%) | RET 568 (10^9/L) |
| MCV 55 (fL) | |
Sickle cell anemia.
Aniso-poikilocytosis (++). Sickle cells (++). Echinocytes (++). Hypochromic RBCs (++). Reticulocytosis (21%).
To note:
- The white blood cells seem +/- altered,
- Apoptosis is clearly visible, especially on some images of Polynuclear Neutrophils,
- And the presence of Echinocytes (++).
The whole is very evocative of "old" blood and could initially be mistaken as such. However, anemia and the sickle-shaped red blood cells indicate a requirement for hemoglobinopathy investigation.
Echinocyte- small projections on red cell membrane
Sickle red cells
Polynuclear Neutrophils-varied shapes and sizes of a cell's nucleus (the part of the cell that contains chromosomes). The nuclei of PMNs have two or three lobes with deep divisions.
The Effects of an Aged Blood Sample on Blood Smear Morphology
The quality and interpretability of a blood smear are highly dependent on the freshness of the sample. Aged blood samples—those that have been stored for prolonged periods, especially at room temperature—can introduce a range of artefactual changes that may complicate or compromise hematological interpretation.
1.Morphological Changes in Aged Samples
Over time, cellular components within a blood sample begin to degrade. This degradation is particularly evident in blood smears prepared from samples older than 6–8 hours post-collection. The following artefacts are commonly observed:
Red Blood Cells (RBCs):
2. EDTA-Induced Artefacts
Ethylenediaminetetraacetic acid (EDTA) is the anticoagulant of choice for most hematological studies. While it is effective at preventing clotting by chelating calcium, EDTA can induce artefacts over time:
Slides below showing age deterioration:
Red cells showing central area of pallor & Rouleaux formation
Crenated & distorted red cells, platelet aggregation
To ensure accurate morphological interpretation, blood smears should ideally be prepared within 2–4 hours of collection. Delays beyond this window, especially when samples are stored at room temperature, can significantly alter cellular morphology due to both natural degradation and EDTA-induced artefacts. Awareness of these changes is essential for laboratory professionals to distinguish between true pathology and pre-analytical artefacts.
What is the best course of action when seeing numerous features as below in the tail of the smear with the following results?
| WBC 8.60 (10^3/mm3) | MCH 29.6 (pg) |
| RBC 3.21 (10^6/mm3) | MCHC 32.6 (g/dL) |
| HGB 9.5 (g/dL) | PLT 222* (10^3/mm3) |
| HCT 29.1 (%) | RDWsd 40.3 (fL) |
| MCV 90.7 (fL) | RDWcv 12.3 (%) |
a) Ignore the features as they are in the tail of the smear.
b) Manually check the sample for clots. Comment on the fact that the platelet count may be underestimated and request a repeat.
c) Query if Microfilaria is present.
Answers are revealed two weeks after launch—check your inbox, our socials (LinkedIn / Facebook / X), or the next issue.
Name the cell and what may it indicate?
The Answer:
The cell shown is known as a Band cell or Stab cell; if numerous are present in the blood smear, it is an indicator of infection or inflammation. Gross red cells abnormalities with large platelets and platelet clumps in a Beta Thalassemia patient. Platelet production and their function in hemostasis and infection.